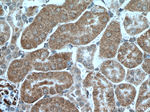
PCK2 Antibody in Immunohistochemistry (Paraffin) (IHC (P))

Search
Proteintech
PCK2 Polyclonal Antibody
{{$productOrderCtrl.translations['antibody.pdp.commerceCard.promotion.promotions']}}
{{$productOrderCtrl.translations['antibody.pdp.commerceCard.promotion.viewpromo']}}
{{$productOrderCtrl.translations['antibody.pdp.commerceCard.promotion.promocode']}}: {{promo.promoCode}} {{promo.promoTitle}} {{promo.promoDescription}}. {{$productOrderCtrl.translations['antibody.pdp.commerceCard.promotion.learnmore']}}
产品信息
14892-1-AP
种属反应
已发表种属
宿主/亚型
分类
类型
抗原
偶联物
形式
浓度
规格
纯化类型
保存液
内含物
保存条件
运输条件
产品详细信息
Immunogen sequence: AGKKRYVAA AFPSACGKTN LAMMRPALPG WKVECVGDDI AWMRFDSEGR LRAINPENGF FGVAPGTSAT TNPNAMATIQ SNTIFTNVAE TSDGGVYWEG IDQPLPPGVT VTSWLGKPWK PGDKEPCAHP NSRFCAPARQ CPIMDPAWEA PEGVPIDAII FGGRRPKGVP LVYEAFNWRH GVFVGSAMRS ESTAAAEHKG KIIMHDPFAM RPFFGYNFGH YLEHWLSMEG RKGAQLPRIF HVNWFRRDEA GHFLWPGFGE NARVLDWICR RLEGEDSARE TPIGLVPKEG ALDLSGLRAI DTTQLFSLPK DFWEQEVRDI RSYLTEQVNQ DLPKEVLAEL EALERRVHKM (292-640 aa encoded by BC001454)
靶标信息
This gene encodes a member of the phosphoenolpyruvate carboxykinase (GTP) family. The protein is a mitochondrial enzyme that catalyzes the conversion of oxaloacetate to phosphoenolpyruvate in the presence of GTP. A cytosolic form encoded by a different gene has also been characterized and is the key enzyme of gluconeogenesis in the liver. The encoded protein may serve a similar function, although it is constitutively expressed and not modulated by hormones such as glucagon and insulin that regulate the cytosolic form. Alternatively spliced transcript variants have been described.
仅用于科研。不用于诊断过程。未经明确授权不得转售。
生物信息学
蛋白别名: epididymis secretory sperm binding protein; HGNC:8725; mtPCK2; PCK2; PEP carboxykinase; PEPCK-M; phosphoenolpyruvate carboxykinase 2 (mitochondrial) isoform PCK2_1; phosphoenolpyruvate carboxykinase 2 (mitochondrial) isoform PCK2_2; phosphoenolpyruvate carboxykinase 2 (mitochondrial) isoform PCK2_3; Phosphoenolpyruvate carboxykinase 2, mitochondrial; Phosphoenolpyruvate carboxykinase [GTP], mitochondrial; phosphoenolpyruvate carboxylase; phosphopyruvate carboxylase; Serine/threonine-protein kinase PCK2; unnamed protein product
基因别名: 1810010O14Rik; 9130022B02Rik; mtPCK2; PCK2; PEPCK; PEPCK-M; PEPCK2
UniProt ID: (Human) Q16822, (Mouse) Q8BH04
Entrez Gene ID: (Human) 5106, (Mouse) 74551, (Rat) 361042